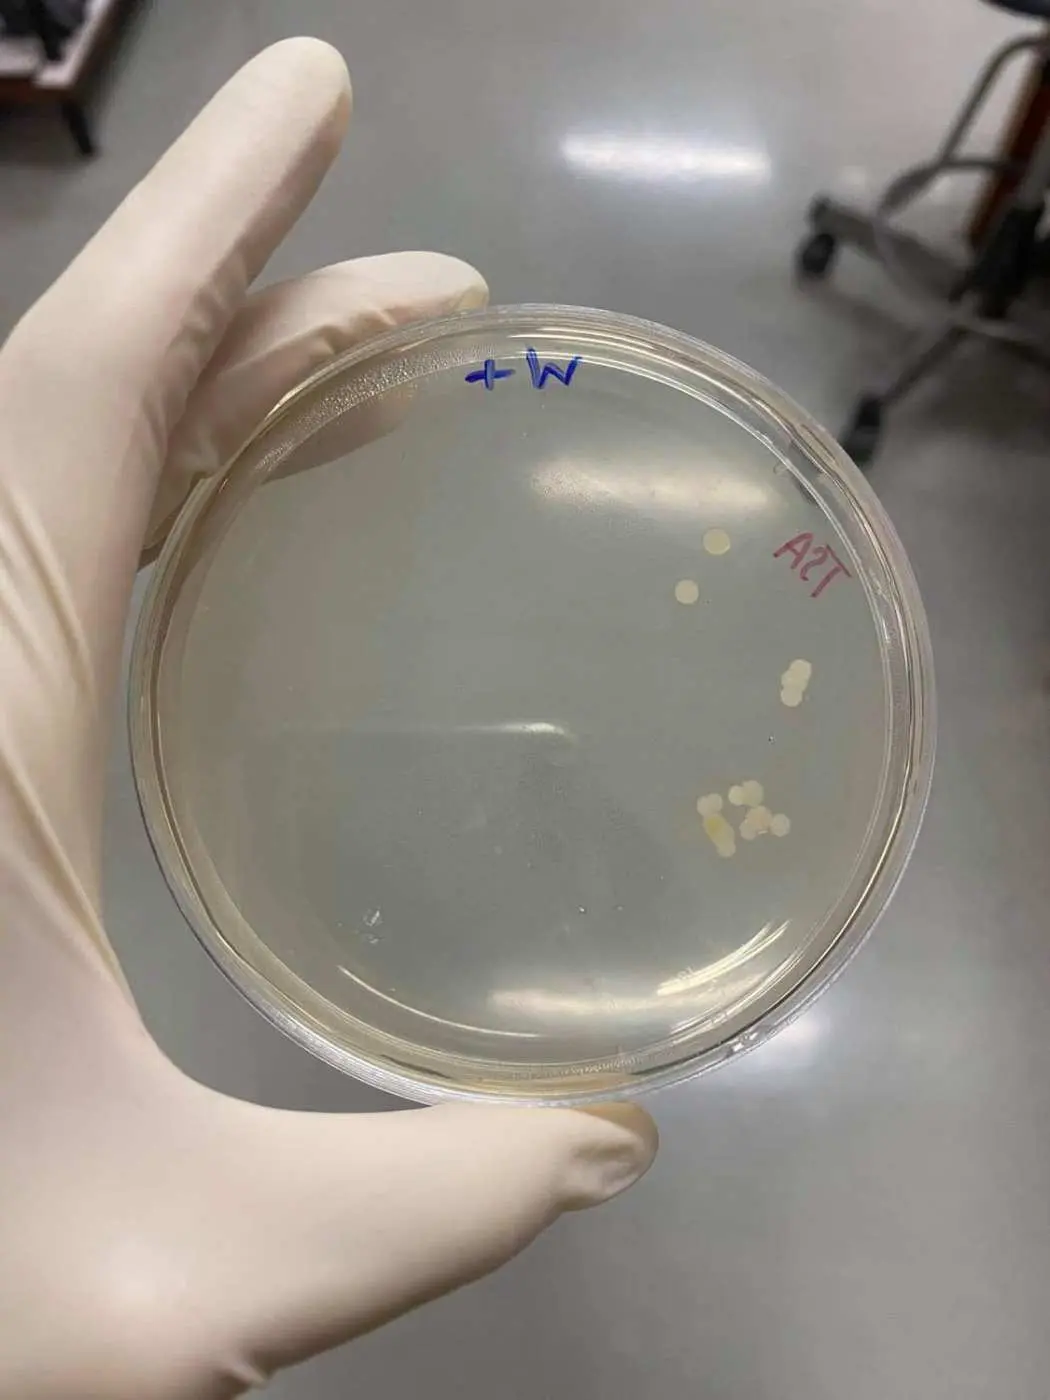

เจลแอลกอฮอล์ สกปรก – ในช่วงการระบาดของไวรัสโควิด – 19เรามักจะพบเห็นขวดเจลแอลกอฮอล์ตามห้างร้าน หรือ ที่สาธารณะให้กดฟรี แห่หารู้ไม่ว่า การที่แอลกอฮอล์โดนความร้อนนั้น จะทำให้เสื่อมสภาพและไม่สามารถฆ่าเชื่อโรคได้ซ้ำยังหัวกดเจลยังเป็นแหล่งสะสมของเชื้อโรคอีกด้วย

ผู้ใช้เฟซบุ๊กรายหนึ่งได้โพสต์ภาพผลการทดลอง ขวดเจลแอลกอฮอล์ โดยมีรายละเอียดว่า
“คืออยากตั้งคำถามว่า ที่กดแอลกอฮอล์สาธารณะนี่มันน่าเชื่อถือขนาดไหนกันนะ ภาพนี้คงตอบได้
-W คือ มือเปล่า ก่อนล้าง
+W คือ ล้างมือด้วยน้ำเปล่า 30วิ แบบถูกต้องอ่ะนะ
-ROH คือ มือเปล่า ก่อนล้าง
+ROH คือ กดแอลกอฮอล์เจลใต้ตึก แล้วถูเหมือนล้างมือ 30วิเท่ากัน
ให้ภาพบอกละกัน ว่าอะไรทำความสะอาดมือได้ดีกว่ากัน.
ปล. เป็นไปได้ว่า พวกเจลแอลที่ตั้งไว้ตามตึก โดนแดดโดนความร้อน มันจะทำให้ แอลฯ ระเหยและเสื่อมประสิทธิภาพไปหมดแล้ว”

ขอบคุณข้อมูลจาก Naravut Suvannang











